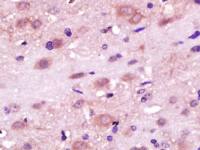
RLBP1L1视黄醛结合蛋白1抗体

相关产品推荐更多 >
万千商家帮你免费找货
0 人在求购买到急需产品
- 详细信息
- 技术资料
- 供应商:
上海联迈生物工程有限公司
- 库存:
大量
- 目录编号:
LM-5864R
- 克隆性:
多克隆
- 抗原来源:
Rabbit
- 保质期:
1年
- 抗体英文名:
ADAMTSL4
- 抗体名:
整合素样金属蛋白酶与凝血酶样4蛋白抗体
- 宿主:
Rabbit
- 适应物种:
Human, Mouse, Rat, Dog, Pig, Cow, Horse, Sheep,
- 免疫原:
KLH conjugated synthetic peptide derived from human ADAMTSL4:351-450/1074
- 亚型:
IgG
- 形态:
Lyophilized or Liquid
- 应用范围:
WB=1:500-2000 ELISA=1:500-1000 IHC-P=1:400-800 IHC-F=1:400-800 IF=1:100-500 (石蜡切片需做抗原修复)
- 浓度:
1mg/ml
- 保存条件:
Store at -20 °C
- 规格:
100ul 200ul
ADAMTSL4整合素样金属蛋白酶与凝血酶样4蛋白抗体
| 英文名称 | ADAMTSL4 |
| 中文名称 | 整合素样金属蛋白酶与凝血酶样4蛋白抗体 |
| 别 名 | ADAMTS like 4; ADAMTS like protein 4; ADAMTSL-4; ADAMTSL 4; Thrombospondin repeat containing 1; thrombospondin repeat protein 1; TSRC1; ATL4_HUMAN. |
| 规格价格 | 100ul/1380元 购买 200ul/2200元 购买 大包装/询价 |
| 说 明 书 | 100ul 200ul |
| 研究领域 | 肿瘤 细胞生物 免疫学 信号转导 细胞粘附分子 |
| 抗体来源 | Rabbit |
| 克隆类型 | Polyclonal |
| 交叉反应 | Human, Mouse, Rat, Dog, Pig, Cow, Horse, Sheep, |
| 产品应用 | WB=1:500-2000 ELISA=1:500-1000 IHC-P=1:400-800 IHC-F=1:400-800 IF=1:100-500 (石蜡切片需做抗原修复) not yet tested in other applications. optimal dilutions/concentrations should be determined by the end user. |
| 分 子 量 | 114kDa |
| 细胞定位 | 细胞外基质 分泌型蛋白 |
| 性 状 | Lyophilized or Liquid |
| 浓 度 | 1mg/ml |
| 免 疫 原 | KLH conjugated synthetic peptide derived from human ADAMTSL4:351-450/1074 |
| 亚 型 | IgG |
| 纯化方法 | affinity purified by Protein A |
| 储 存 液 | 0.01M TBS(pH7.4) with 1% BSA, 0.03% Proclin300 and 50% Glycerol. |
| 保存条件 | Store at -20 °C for one year. Avoid repeated freeze/thaw cycles. The lyophilized antibody is stable at room temperature for at least one month and for greater than a year when kept at -20°C. When reconstituted in sterile pH 7.4 0.01M PBS or diluent of antibody the antibody is stable for at least two weeks at 2-4 °C. |
| PubMed | PubMed |
| 产品介绍 | background: ADAMTSL4 is a member of ADAMTS (a disintegrin and metalloproteinase with thrombospondin motifs)-like family and has seven thrombospondin type 1 repeats. The thrombospondin type 1 repeat domain is found in many proteins with diverse biological functions including cellular adhesion, angiogenesis, and patterning of the developing nervous system. Alternate transcriptional splice variants, encoding different isoforms, have been characterized. ADAMTSL4 is involved in the positive regulation of apoptosis. Function: Positive regulation of apoptosis. May facilitate FBN1 microfibril biogenesis. Subunit: Interacts with CTSB. Interacts with FBN1. Subcellular Location: Secreted, extracellular space, extracellular matrix. Note=Colocalizes with FMN1 microfibrils in the eye ECM. Tissue Specificity: Expressed in colon, heart, leukocyte, liver, lung, skeletal muscle, spleen, testis and placenta. Weaker expression in bone marrow, brain tissue, kidney and pancreas. Expression studies in fetal tissues reveal strong expression in heart, kidney, liver, lung and skeletal muscle, but weaker expression in fetal brain and skin. Post-translational modifications: N-glycosylated. Can be O-fucosylated by POFUT2 on a serine or a threonine residue found within the consensus sequence C1-X(2)-(S/T)-C2-G of the TSP type-1 repeat domains where C1 and C2 are the first and second cysteine residue of the repeat, respectively. Fucosylated repeats can then be further glycosylated by the addition of a beta-1,3-glucose residue by the glucosyltransferase, B3GALTL. Fucosylation mediates the efficient secretion of ADAMTS family members. Also can be C-glycosylated with one or two mannose molecules on tryptophan residues within the consensus sequence W-X-X-W of the TPRs. N- and C-glycosylations can also facilitate secretion (By similarity). DISEASE: Defects in ADAMTSL4 are a cause of ectopia lentis, isolated, autosomal recessive (ECTOL2) [MIM:225100]. A rare condition characterized by partial or complete displacement of the lens from its space resulting from defective zonule formation. Similarity: Contains 1 PLAC domain. Contains 6 TSP type-1 domains. SWISS: Q6UY14 Gene ID: 54507 Database links: Entrez Gene: 54507 Human Omim: 610113 Human SwissProt: Q6UY14 Human Important Note: This product as supplied is intended for research use only, not for use in human, therapeutic or diagnostic applications. 细胞外基质蛋白 |
| 产品图片 | ![]() Sample: Lung (Mouse) Lysate at 40 ug Primary: Anti- ADAMTSL4 (bs-5864R) at 1/1000 dilution Secondary: IRDye800CW Goat Anti-Rabbit IgG at 1/20000 dilution Predicted band size: 114 kD Observed band size: 124 kD ![]() Sample: Heart (Mouse) Lysate at 40 ug Primary: Anti- ADAMTSL4 (bs-5864R) at 1/1000 dilution Secondary: IRDye800CW Goat Anti-Rabbit IgG at 1/20000 dilution Predicted band size: 114 kD Observed band size: 124 kD ![]() Sample: Heart (Mouse) Lysate at 40 ug Primary: Anti- ADAMTSL4 (bs-5864R) at 1/1000 dilution Secondary: IRDye800CW Goat Anti-Rabbit IgG at 1/20000 dilution Predicted band size: 114 kD Observed band size: 124 kD |
风险提示:丁香通仅作为第三方平台,为商家信息发布提供平台空间。用户咨询产品时请注意保护个人信息及财产安全,合理判断,谨慎选购商品,商家和用户对交易行为负责。对于医疗器械类产品,请先查证核实企业经营资质和医疗器械产品注册证情况。
技术资料暂无技术资料 索取技术资料
ADAMTSL4整合素样金属蛋白酶与凝血酶样4蛋白抗体
¥1380 - 2200